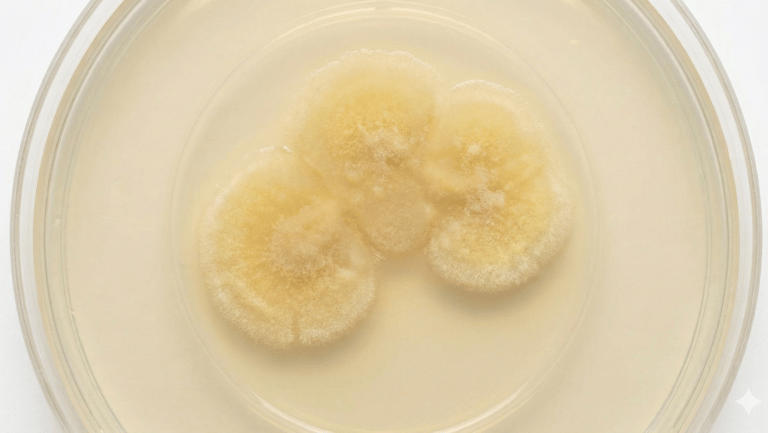
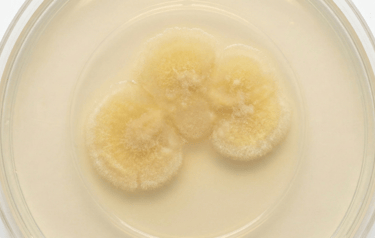

The Source of the Germs
This shows a close-up of a worn and dirty baseball cap. The sweatband is stained with sweat and grime, making it a breeding ground for bacteria. A cotton swab is shown collecting a sample from the soiled fabric.
Culturing the Bacteria
After swabbing the dirty cap, the sample was transferred to a petri dish containing a nutrient-rich agar gel. This image shows the result after incubation: a large, fuzzy, yellowish bacterial colony has grown, demonstrating the presence of significant microbial life on the cap's surface.
A Microscopic View
Finally, a sample of the bacterial colony from the petri dish was examined under a high-powered microscope. This image reveals the individual bacteria, which are rod-shaped (bacilli) and have been stained purple for visibility. These are the millions of individual organisms that make up the colony seen in the previous image, all originating from the dirty sport cap.
CLNcap detergent sheets, solve this problem
Plant-based detergent sheets that refresh your baseball caps in the dishwasher.


CLN cap
Dishwasher sheets rejuvenate your baseball caps with ease, leaving them smelling fresh and eliminating bacteria and germs.






CLNcap
The bacteria, germ free solution
Contact
Newsletter
info@clncap.com
619-423-5702
© 2026. All rights reserved.
